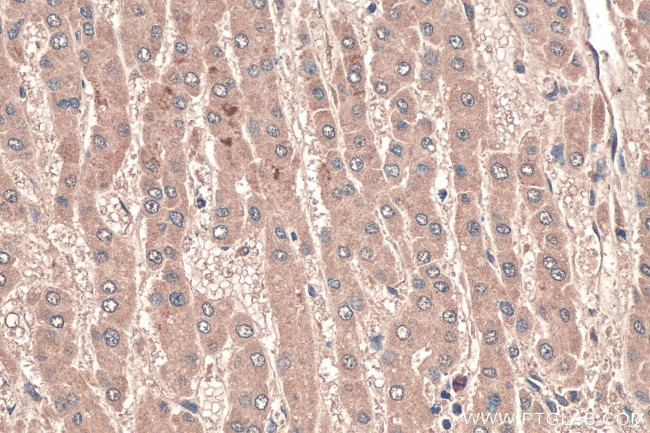
LPIN1 Antibody in Immunohistochemistry (Paraffin) (IHC (P))

Search
Proteintech
LPIN1 Monoclonal Antibody (3G11B10)
{{$productOrderCtrl.translations['antibody.pdp.commerceCard.promotion.promotions']}}
{{$productOrderCtrl.translations['antibody.pdp.commerceCard.promotion.viewpromo']}}
{{$productOrderCtrl.translations['antibody.pdp.commerceCard.promotion.promocode']}}: {{promo.promoCode}} {{promo.promoTitle}} {{promo.promoDescription}}. {{$productOrderCtrl.translations['antibody.pdp.commerceCard.promotion.learnmore']}}
产品信息
68124-1-IG150UL
种属反应
宿主/亚型
分类
类型
克隆号
偶联物
形式
浓度
规格
纯化类型
保存液
内含物
保存条件
运输条件
靶标信息
The Lipin family of nuclear proteins contains three members: Lipin-1, Lipin-2 and Lipin-3, all of which contain a nuclear signal sequence, a highly conserved amino-terminal (NLIP) domain and a carboxy-terminal (CLIP) domain. LPIN1 (Lipin-1) is crucial for normal adipose tissue development and metabolism. LPIN1 selectively activates a subset of PGC-1A; target pathways, including fatty acid oxidation and mitochondrial oxidative phosphorylation by inducing expression of the nuclear receptor PPARA. LPIN1 also inactivates the lipogenic program and suppresses circulating lipid levels. An abundance of LPIN1 promotes fat accumulation and insulin sensitivity, whereas a deficiency in LPIN1 may deter normal adipose tissue development, resulting in insulin resistance and lipodystrophy, a heterogeneous group of disorders characterized by loss of body fat, fatty liver, hypertriglyceridemia and insulin resistance.
仅用于科研。不用于诊断过程。未经明确授权不得转售。
篇参考文献 (0)
生物信息学
蛋白别名: DKFZp781P1796; Fatty liver dystrophy protein; KIAA0188; Lipin-1; Phosphatidate phosphatase LPIN1; unnamed protein product
基因别名: 4631420P06; fld; Flde; KIAA0188; Lipin1; LPIN1; mKIAA0188; PAP1
UniProt ID: (Human) Q14693, (Mouse) Q91ZP3
Entrez Gene ID: (Human) 23175, (Rat) 313977, (Mouse) 14245